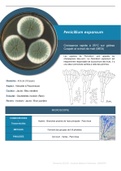
Product Image

Pack
Mycologie Vétérinaire
Note combinée
Documents
15
Vendu
-
Nombre total de pages
15
Dernière mise à jour
21-02-2023
Pack regroupant les fiches récapitulatives des espèces et genres de champignons d'intérêt vétérinaire.
Documents dans ce pack
15

Resume
Résumé MYCOLOGIE - Alternaria alternata - Fiche récapitulative 1 page
-
1
Feb 2023
2021/2022
€6,49

Resume
Résumé MYCOLOGIE - Aspergillus flavus - Fiche récapitulative 1 page
-
1
Feb 2023
2021/2022
€6,49

Resume
Résumé MYCOLOGIE - Aspergillus fumigatus - Fiche récapitulative 1 page
-
1
Feb 2023
2020/2021
€6,49

Resume
Résumé MYCOLOGIE - Aspergillus niger - Fiche récapitulative 1 page
-
1
Feb 2023
2021/2022
€6,49

Resume
Résumé MYCOLOGIE - Fusarium spp. - Fiche récapitulative 1 page
-
1
Feb 2023
2021/2022
€6,49
Resume
Résumé MYCOLOGIE - Penicillium expansum - Fiche récapitulative 1 page
-
1
Feb 2023
2020/2021
€6,49

Resume
Résumé MYCOLOGIE - Penicillium spp. - Fiche récapitulative 1 page
-
1
Feb 2023
2021/2022
€6,49
20,49 €
97,35 €
Vous économisez 76,86 €
Économisez 79% sur 15 documents
Garantie de satisfaction à 100%
Disponible immédiatement après paiement
En ligne et en PDF
Tu n'es attaché à rien















